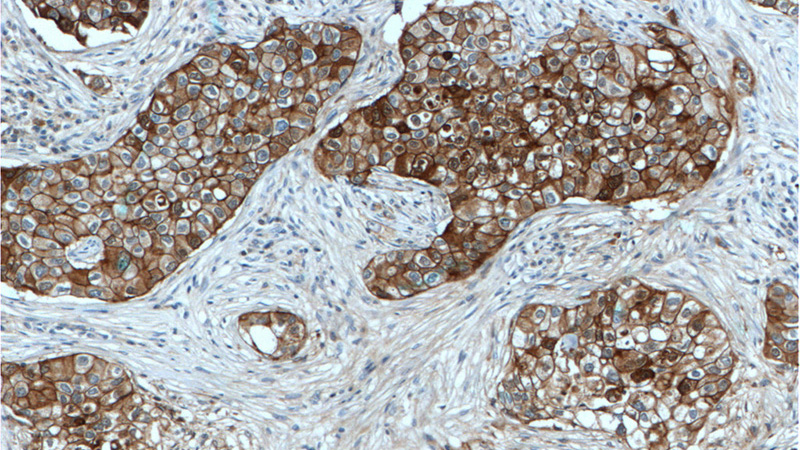
Immunohistochemistry of paraffin-embedded human breast cancer tissue slide using Catalog No:107244(E-cadherin Antibody) at dilution of 1:300 (under 10x lens). Heat mediated antigen retrieved with Tris-EDTA buffer(pH9).

-
Product Name
E-cadherin antibody
- Documents
-
Description
E-cadherin Mouse Monoclonal antibody. Positive WB detected in A431 cells, MCF-7 cells. Positive IHC detected in human breast cancer tissue. Positive IF detected in human breast cancer tissue. Observed molecular weight by Western-blot: 120 kDa
-
Tested applications
ELISA, IHC, IF, WB
-
Species reactivity
Human; other species not tested.
-
Alternative names
Arc 1 antibody; Cadherin 1 antibody; CAM 120/80 antibody; CD324 antibody; CDH1 antibody; CDHE antibody; E cadherin antibody; ECAD antibody; E-cadherin antibody; Epithelial cadherin antibody; LCAM antibody; UVO antibody; Uvomorulin antibody
-
Isotype
Mouse IgG2b
-
Preparation
This antibody was obtained by immunization of E-cadherin recombinant protein (Accession Number: BC141838). Purification method: Protein A purified.
-
Clonality
Monoclonal
-
Formulation
PBS with 0.02% sodium azide and 50% glycerol pH 7.3.
-
Storage instructions
Store at -20℃. DO NOT ALIQUOT
-
Applications
Recommended Dilution:
WB: 1:2000-1:20000
IHC: 1:50-1:500
IF: 1:50-1:500
-
Validations

A431 cells were subjected to SDS PAGE followed by western blot with Catalog No:107244(E-cadherin Antibody) at dilution of 1:8000

Immunofluorescent analysis of (4% PFA) fixed human breast cancer tissue using Catalog No:107244 (E-cadherin Antibody) at dilution of 1:250 and Alexa Fluor 488-congugated AffiniPure Goat Anti-Mouse IgG(H+L)
Immunohistochemistry of paraffin-embedded human breast cancer tissue slide using Catalog No:107244(E-cadherin Antibody) at dilution of 1:300 (under 10x lens). Heat mediated antigen retrieved with Tris-EDTA buffer(pH9).

Immunohistochemistry of paraffin-embedded human breast cancer tissue slide using Catalog No:107244(E-cadherin Antibody) at dilution of 1:300 (under 40x lens). Heat mediated antigen retrieved with Tris-EDTA buffer(pH9).
-
Background
Cadherins are a family of transmembrane glycoproteins that mediate calcium-dependent cell-cell adhesion and play an important role in the maintenance of normal tissue architecture. E-cadherin (epithelial cadherin), also known as CDH1 (cadherin 1) or CAM 120/80, is a classical member of the cadherin superfamily which also include N-, P-, R-, and B-cadherins. It has been regarded as a marker for spermatogonial stem cells in mice(PMID:23509752). E-cadherin is expressed on the cell surface in most epithelial tissues. The extracellular region of E-cadherin establishes calcium-dependent homophilic trans binding, providing specific interaction with adjacent cells, while the cytoplasmic domain is connected to the actin cytoskeleton through the interaction with p120-, α-, β-, and γ-catenin (plakoglobin). E-cadherin is important in the maintenance of the epithelial integrity, and is involved in mechanisms regulating proliferation, differentiation, and survival of epithelial cell. E-cadherin may also play a role in tumorigenesis. It is considered to be an invasion suppressor protein and its loss is an indicator of high tumor aggressiveness.
Related Products / Services
Please note: All products are "FOR RESEARCH USE ONLY AND ARE NOT INTENDED FOR DIAGNOSTIC OR THERAPEUTIC USE"
